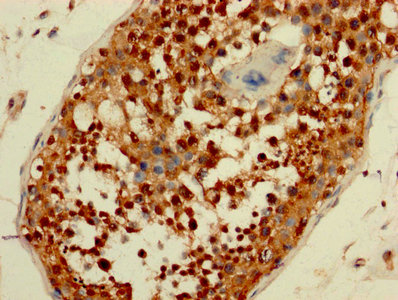

AATF Antibody
-
中文名稱:AATF兔多克隆抗體
-
貨號:CSB-PA05264A0Rb
-
規格:¥440
-
圖片:
-
IHC image of CSB-PA05264A0Rb diluted at 1:200 and staining in paraffin-embedded human testis tissue performed on a Leica BondTM system. After dewaxing and hydration, antigen retrieval was mediated by high pressure in a citrate buffer (pH 6.0). Section was blocked with 10% normal goat serum 30min at RT. Then primary antibody (1% BSA) was incubated at 4°C overnight. The primary is detected by a biotinylated secondary antibody and visualized using an HRP conjugated SP system.
-
-
其他:
產品詳情
-
產品名稱:Rabbit anti-Homo sapiens (Human) AATF Polyclonal antibody
-
Uniprot No.:
-
基因名:
-
別名:AATF antibody; AATF_HUMAN antibody; Apoptosis antagonizing transcription factor antibody; Apoptosis-antagonizing transcription factor antibody; BFR2 antibody; CHE 1 antibody; CHE1 antibody; DED antibody; Protein AATF antibody; Rb binding protein Che 1 antibody; Rb-binding protein Che-1 antibody
-
宿主:Rabbit
-
反應種屬:Human
-
免疫原:Recombinant Human Protein AATF protein (6-294AA)
-
免疫原種屬:Homo sapiens (Human)
-
標記方式:Non-conjugated
本頁面中的產品,AATF Antibody (CSB-PA05264A0Rb),的標記方式是Non-conjugated。對于AATF Antibody,我們還提供其他標記。見下表:
-
克隆類型:Polyclonal
-
抗體亞型:IgG
-
純化方式:>95%, Protein G purified
-
濃度:It differs from different batches. Please contact us to confirm it.
-
保存緩沖液:Preservative: 0.03% Proclin 300
Constituents: 50% Glycerol, 0.01M PBS, PH 7.4 -
產品提供形式:Liquid
-
應用范圍:ELISA, IHC
-
推薦稀釋比:
Application Recommended Dilution IHC 1:200-1:500 -
Protocols:
-
儲存條件:Upon receipt, store at -20°C or -80°C. Avoid repeated freeze.
-
貨期:Basically, we can dispatch the products out in 1-3 working days after receiving your orders. Delivery time maybe differs from different purchasing way or location, please kindly consult your local distributors for specific delivery time.
-
用途:For Research Use Only. Not for use in diagnostic or therapeutic procedures.
相關產品
靶點詳情
-
功能:May function as a general inhibitor of the histone deacetylase HDAC1. Binding to the pocket region of RB1 may displace HDAC1 from RB1/E2F complexes, leading to activation of E2F target genes and cell cycle progression. Conversely, displacement of HDAC1 from SP1 bound to the CDKN1A promoter leads to increased expression of this CDK inhibitor and blocks cell cycle progression. Also antagonizes PAWR mediated induction of aberrant amyloid peptide production in Alzheimer disease (presenile and senile dementia), although the molecular basis for this phenomenon has not been described to date.
-
基因功能參考文獻:
- Results show that Che-1 protects colon cancer cells from apoptosis induced by hypoxia through its ability to regulate HIF1-alpha stabilization in colorectal cancer cells. PMID: 28214471
- Results show that eEF1Bgamma binds to the Che-1 promoter region and its transcript, and describe a novel mitochondrial localization for the Che-1 protein which needs mitochondrial integrity for correct localization. PMID: 27639846
- we identified the ANN complex as a novel functional module supporting the nucleolar maturation of 40S ribosomal subunits. Our data help to explain the described role of AATF in cell proliferation during mouse development as well as its requirement for malignant tumor growth. PMID: 27599843
- the effect of APOBEC3G over-expression upon AATF gene expression, was examined. PMID: 27611213
- loss of Che-1 inhibits proliferation and promotes apoptosis in MG-63 cells by decreasing the level of mutant p53 PMID: 27012205
- It was concluded that PARP-1 was involved in the DNA damage repair induced by HQ via increasing the accumulation of apoptosis antagonizing transcription factor through PARylation. PMID: 26822515
- These results confirm Che-1 as an important regulator of p53 activity and suggest Che-1 to be a promising yet attractive drug target for cancer therapy. PMID: 25996291
- In the face of high glucose threat, mitochondrial UCP2 gene expression is regulated by miR-2909 and AATF. PMID: 25976474
- This mutant AATF along with its interactome consisting of SP1, DNMT3B and Par-4 ensures cancer cell DNA methylation required for down-regulation of tumor suppressor genes. PMID: 25231211
- HIPK2 depletion strongly decreases Che-1 ubiquitylation and degradation. PMID: 25210797
- Che-1 expression correlates with the progression of multiple myeloma and is required for cell growth and survival.Che-1 controls mTOR through the induction of Redd1 and Deptor, two important repressors of mTOR. PMID: 25770584
- Cell proliferation decreased by 41% which was accompanied by apoptosis induction in 30% MCF-7 cells after AATF gene knockdown. PMID: 23801113
- Che-1 depletion abolishes the ability of Chk1 to bind pericentrin and to localize at centrosomes, which, in its turn, deregulates the activation of centrosomal cyclin B-Cdk1 and advances entry into mitosis. PMID: 23798705
- These results identify AATF as a nucleolar-confined c-Jun cofactor whose expression levels and spatial distribution determine the stress-induced activity of c-Jun and the levels of c-Jun-mediated apoptosis. PMID: 22933572
- Nuclear AATF enrichment is selected for in p53-proficient endometrial cancers. Focal copy number AATF gains correlate with reduced overall survival in neuroblastoma. AATF is a critical repressor of p53-driven apoptosis. PMID: 22909821
- found that Che-1 is required for sustaining mutant p53 expression in several cancer cell lines, and that Che-1 depletion by siRNA induces apoptosis both in vitro and in vivo PMID: 20708154
- No evidence for the association of mutations with breast cancer was observed. PMID: 20025740
- Che-1 affects cell growth by interfering with the recruitment of HDAC1 by retinoblastoma protein. Che-1 overexpression activates DNA synthesis in quiescent NIH-3T3 cells through HFDAC1 displacement. PMID: 12450794
- Che-1 can be considered a general HDAC1 competitor and its down-regulation is involved in colon carcinoma cell proliferation PMID: 12847090
- apoptosis-antagonizing transcription factor binds to TSG101 in a process that enhances androgen receptor-mediated transcription by promoting its monoubiquitination PMID: 14761944
- AATF gene may be of crucial importance in maintaining the leukemic state of a cell compartment through its ability to initiate cell proliferation coupled with repression of cellular apoptosis. PMID: 17006618
- Che-1 as a new Pin1 and HDM2 target and confirm its important role in the cellular response to DNA damage. PMID: 17468107
- Che-1 interacts with NRAGE and NRAGE overexpression downregulates endogenous Che-1 by targeting it for proteasome-dependent degradation. PMID: 17488777
- This review explains the novel miRNA encoded exclusively by HIV-1 genome that has the ability to specifically target cellular AATF gene known to play a crucial role in the maintenance of adaptive immunity at nucleic acid level against HIV-1 invasion. PMID: 18341201
顯示更多
收起更多
-
亞細胞定位:Nucleus, nucleolus.
-
蛋白家族:AATF family
-
組織特異性:Ubiquitously expressed. Expressed at high levels in brain, heart, kidney, placenta and thymus.
-
數據庫鏈接:
Most popular with customers
-
-
YWHAB Recombinant Monoclonal Antibody
Applications: ELISA, WB, IHC, IF, FC
Species Reactivity: Human, Mouse, Rat
-
Phospho-YAP1 (S127) Recombinant Monoclonal Antibody
Applications: ELISA, WB, IHC
Species Reactivity: Human
-
-
-
-
-